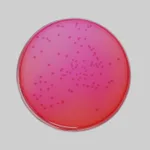

Himedia B12 Assay Medium (Using L. leichmannii)
상품 한눈에 보기
Lactobacillus leichmannii 생육을 위한 비타민 B12 무첨가 배지로, B12 농도 분석에 사용됩니다. 표준 곡선을 통해 시료 내 비타민 B12 농도를 정량할 수 있습니다. 미생물학적 비타민 분석용으로 적합합니다.
브랜드: Himedia
✨AI 추천 연관 상품
AI가 분석한 이 상품과 연관된 추천 상품들을 확인해보세요
연관 상품을 찾고 있습니다...
제품 설명
이 배지는 Lactobacillus leichmannii ATCC 7830의 생육에 필요한 모든 비타민과 영양소를 포함하되, 비타민 B12는 포함하지 않은 배지입니다.
시료 내 비타민 B12 농도는 표준 곡선을 작성하고, 흡광도와 비타민 B12 농도의 관계를 해석하여 계산합니다.
제품 스펙
| 항목 | 내용 |
|---|---|
| Product Name | B12 Assay Medium (Using L. leichmannii) |
| SKU | M036 |
| Customized Product Available | No |
응용 분야
- 비타민 B12 정량 분석용 미생물 배양
- 생화학 및 영양학 연구
- 미생물 성장 시험 및 표준화 실험
🏷️Himedia 상품 둘러보기
동일 브랜드의 다른 상품들을 확인해보세요

Himedia
Himedia Fluid Tetrathionate Medium w/o Iodine and BG (Tetrathionate Broth Base w/o Iodine and BG)
44,000원

Himedia
Himedia Deoxycholate Agar
54,000원

Himedia
Himedia B12 Assay Medium (Using L. leichmannii)
120,000원
Himedia
Himedia Xylose Lysine Deoxycholate Agar (XLD Agar)
54,000원

Himedia
Himedia Peptone Water
54,000원
배송/결제/교환/반품 안내
배송 정보
| 기본 배송비 |
| 교환/반품 배송비 |
|
|---|---|---|---|
| 착불 배송비 |
| ||
| 교환/반품 배송비 |
| ||
결제 및 환불 안내
| 결제수단 |
|
|---|---|
| 취소 |
|
| 반품 |
|
| 환급 |
|
교환 및 반품 접수
| 교환 및 반품 접수 기한 |
|
|---|---|
| 교환 및 반품 접수가 가능한 경우 |
|
| 교환 및 반품 접수가 불가능한 경우 |
|
교환 및 반품 신청
| 교환 절차 |
|
|---|---|
| 반품 절차 |
|
문의 0
로그인 후 문의를 할 수 있습니다.